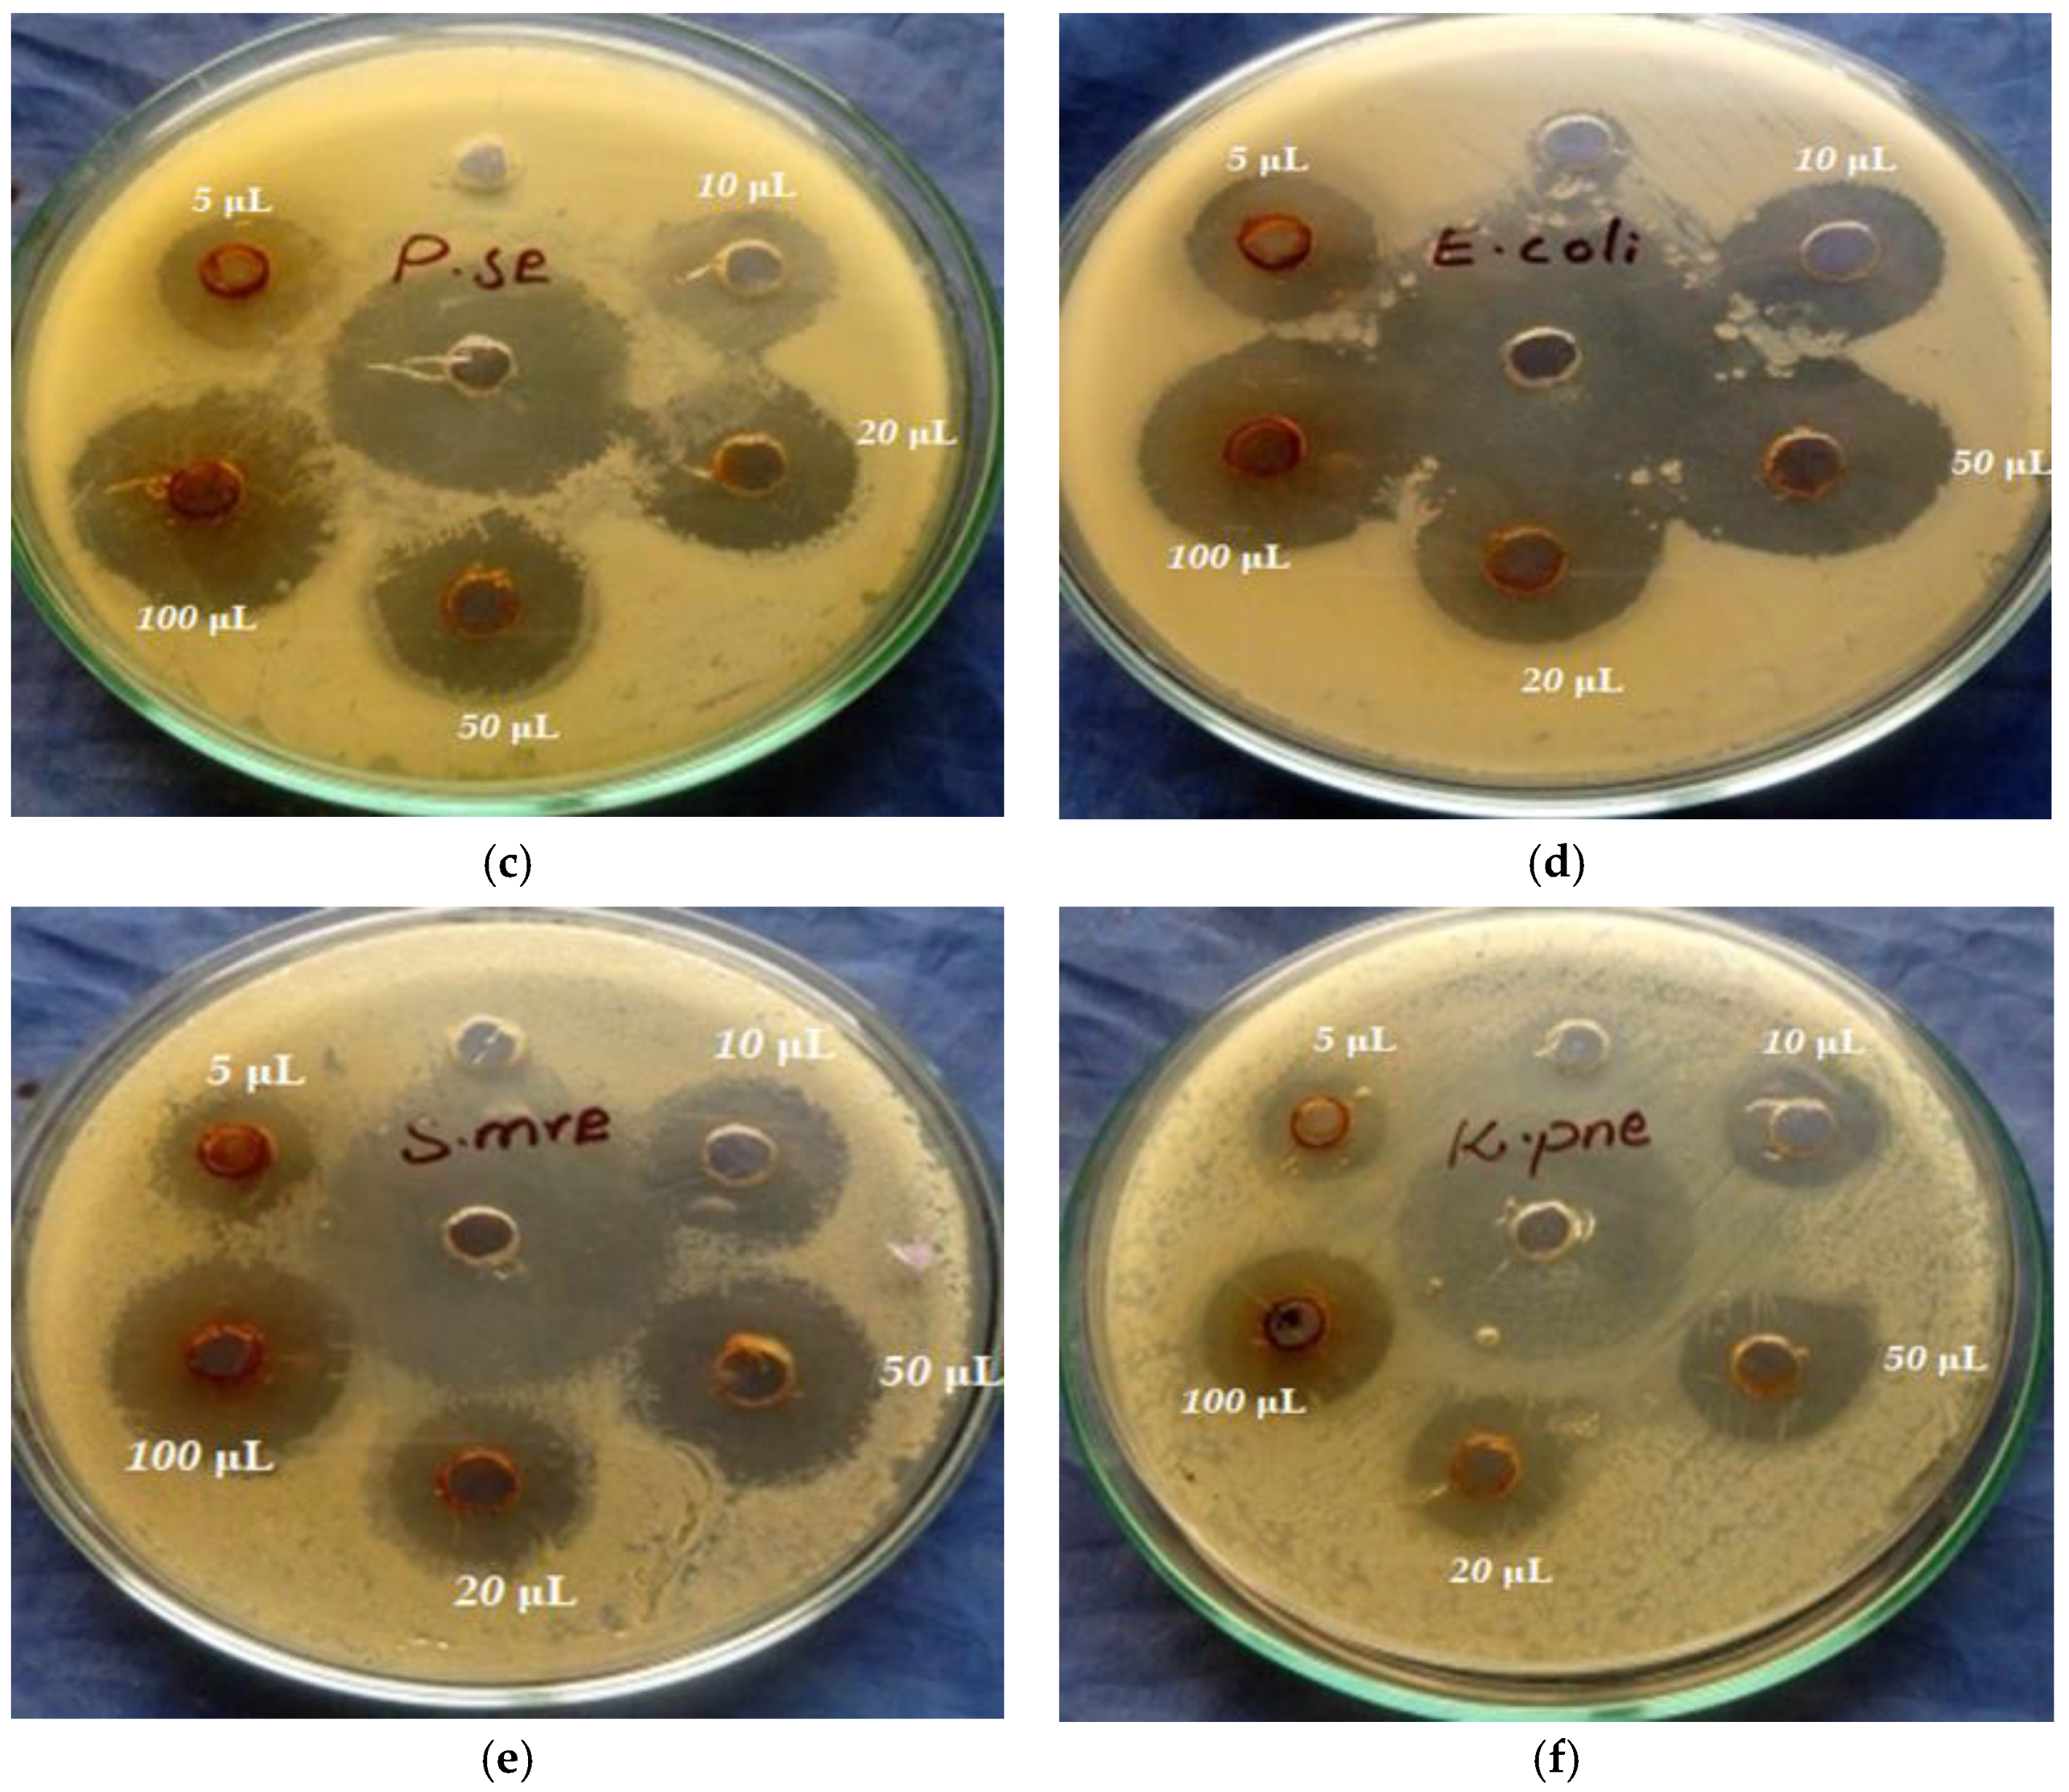

Antibacterial, Antioxidant and Physicochemical Properties of Pipper nigram Aided Copper Oxide Nanoparticles
Abstract
1. Introduction
2. Materials and Methods
2.1. Chemical Used
2.2. Preparation of Extract
2.3. Synthesis of CuO NPs
2.4. Characterization
2.5. Antibacterial Assay
2.6. Antioxidant Assay
3. Results
3.1. XRD Analysis
3.2. SEM Analysis
3.3. EDX Analysis
3.4. TGA Analysis
3.5. UV-Visible Analysis
3.6. FTIR Analysis
3.7. Antibacterial Assay
3.8. Antioxidant Assay
3.9. Comparison with Literature
4. Conclusions
Author Contributions
Funding
Data Availability Statement
Acknowledgments
Conflicts of Interest
References
- Haq, S.; Rehman, W.; Waseem, M.; Shah, A.; Khan, A.R. Green synthesis and characterization of tin dioxide nanoparticles for photocatalytic and antimicrobial studies. Mater. Res. Express 2020, 7, 1–9. [Google Scholar] [CrossRef]
- Slavin, Y.N.; Asnis, J.; Häfeli, U.O.; Bach, H. Metal nanoparticles: Understanding the mechanisms behind antibacterial activity. J. Nanobiotechnol. 2017, 15, 1–20. [Google Scholar] [CrossRef] [PubMed]
- Rehana, D.; Mahendiran, D.; Kumar, R.S.; Rahiman, A.K. Evaluation of antioxidant and anticancer activity of copper oxide nanoparticles synthesized using medicinally important plant extracts. Biomed. Pharmacother. 2017, 89, 1067–1077. [Google Scholar] [CrossRef]
- Sannigrahi, S.; Mazumder, U.K.; Pal, D.K.; Parida, S. In vitro anti oxidant activity of methanol extract of Clerodendrum infortunatum Linn. Orient. Pharm. Exp. Med. 2009, 9, 128–134. [Google Scholar] [CrossRef]
- Jones, N.; Ray, B.; Ranjit, K.T.; Manna, A.C. Antibacterial activity of ZnO nanoparticle suspensions on a broad spectrum of microorganisms. FEMS Microbiol. Lett. 2007, 279, 71–76. [Google Scholar] [CrossRef]
- Prasad, S. Nanotechnology in Medicine and Antibacterial Effect of silver nano particles. Dig. J. Nanomater. Biostructures 2008, 3, 115–122. [Google Scholar]
- Demirbas, A.; Welt, B.A.; Ocsoy, I. Biosynthesis of red cabbage extract directed Ag NPs and their effect on the loss of antioxidant activity. Mater. Lett. 2016, 179, 20–23. [Google Scholar] [CrossRef]
- Yadi, M.; Mostafavi, E.; Saleh, B.; Davaran, S.; Aliyeva, I.; Khalilov, R.; Nikzamir, M.; Nikzamir, N.; Akbarzadeh, A.; Panahi, Y.; et al. Current developments in green synthesis of metallic nanoparticles using plant extracts: A review. Artif. Cells Nanomed. Biotechnol. 2018, 46, S336–S343. [Google Scholar] [CrossRef]
- Al-azzawie, H.F.; Yaaqoob, L.A. Hypoglycemic and Antioxidant Effects of gold nanoparticals in alloxan. Original article Hypoglycemic and Antioxidant Effects of gold nanoparticals in alloxan-Induced Diabetes Rats. Int J Res Biotechnol. Biochem. 2016, 6, 12–20. [Google Scholar]
- Altikatoglu, M.; Attar, A.; Erci, F.; Cristache, C.M.; Isildak, I. Green synthesis of copper oxide nanoparticles using ocimum basilicum extract and their antibacterial activity. Fresenius Environ. Bull. 2017, 25, 7832–7837. [Google Scholar]
- Dang, T.M.D.; Le, T.T.T.; Fribourg-Blanc, E.; Dang, M.C. Synthesis and optical properties of copper nanoparticles prepared by a chemical reduction method. Adv. Nat. Sci. Nanosci. Nanotechnol. 2011, 2, 015009. [Google Scholar] [CrossRef]
- Kerli, S. Alver Preparation and characterisation of ZnO/NiO nanocomposite particles for solar cell applications. J. Nanotechnol. 2016, 2016, 4028062. [Google Scholar] [CrossRef]
- Venkateswarlu, K. Ashes from Organic Waste as Reagents in Synthetic Chemistry: A Review; Springer International Publishing: Cham, Switzerland, 2021; Volume 19, pp. 3887–3950. ISBN 0123456789. [Google Scholar]
- Din, M.I.; Arshad, F.; Hussain, Z.; Mukhtar, M. Green Adeptness in the Synthesis and Stabilization of Copper Nanoparticles: Catalytic, Antibacterial, Cytotoxicity, and Antioxidant Activities. Nanoscale Res. Lett. 2017, 12, 638. [Google Scholar] [CrossRef]
- Mohammadinejad, R.; Karimi, S.; Iravani, S.; Varma, R.S. Plant-derived nanostructures: Types and applications. Green Chem. 2015, 18, 20–52. [Google Scholar] [CrossRef]
- Veluswamy, B.; Vaidehi, D.; Logpriya, S. Green synthesis of copper oxide nanoparticles for biological applications. Microbiol. Curr. Res. 2018, 2, 2–4. [Google Scholar] [CrossRef]
- Pathak, G.; Das, D.; Rajkumari, K.; Rokhum, L. Exploiting waste: Towards a sustainable production of biodiesel using: Musa acuminata peel ash as a heterogeneous catalyst. Green Chem. 2018, 20, 2365–2373. [Google Scholar] [CrossRef]
- Naika, H.R.; Lingaraju, K.; Manjunath, K.; Kumar, D.; Nagaraju, G.; Suresh, D.; Nagabhushana, H. Green synthesis of CuO nanoparticles using Gloriosa superba L. extract and their antibacterial activity. J. Taibah Univ. Sci. 2015, 9, 7–12. [Google Scholar] [CrossRef]
- Surmawar, N.V.; Thakare, S.R.; Khaty, N.T. One-pot, single step green synthesis of copper nanoparticles: SPR nanoparticles. Int. J. Green Nanotechnol. Biomed. 2011, 3, 302–308. [Google Scholar] [CrossRef]
- Kollu, P. Green Synthesis of CuO Nanoparticles using Phyllanthus Amarus Leaf Extract and their Antibacterial Activity Against Multidrug Resistance Bacteria. Biol. Int. J. Eng. Res. Technol. 2014, 3, 639–641. [Google Scholar]
- Kumar, P.P.N.V.; Shameem, U.; Kollu, P.; Kalyani, R.L.; Pammi, S.V.N. Green Synthesis of Copper Oxide Nanoparticles Using Aloe vera Leaf Extract and Its Antibacterial Activity Against Fish Bacterial Pathogens. BioNanoScience 2015, 5, 135–139. [Google Scholar] [CrossRef]
- Devi, H.S.; Singh, T.D. Synthesis of Copper Oxide Nanoparticles by a Novel Method and its Application in the Degradation of Methyl Orange. Adv. Electron. Electr. Eng. 2014, 4, 83. [Google Scholar]
- Sankar, R.; Manikandan, P.; Malarvizhi, V.; Fathima, T.; Shivashangari, K.S.; Ravikumar, V. Green synthesis of colloidal copper oxide nanoparticles using Carica papaya and its application in photocatalytic dye degradation. Spectrochim. Acta Part A Mol. Biomol. Spectrosc. 2014, 121, 746–750. [Google Scholar] [CrossRef] [PubMed]
- Anantharaman, A.; George, L.; George, M. Green synthesis of copper oxide nanoparticles and its applications. Green Chem. Lett. Rev. 2022, 15, 522–529. [Google Scholar]
- Haq, S.; Rehman, W.; Waseem, M.; Meynen, V.; Ullah, S.; Saeed, S.; Iqbal, N. Fabrication of pure and moxifloxacin functionalized silver oxide nanoparticles for photocatalytic and antimicrobial activity. J. Photochem. Photobiol. B Biol. 2018, 186, 116–124. [Google Scholar] [CrossRef]
- Nahak, G.; Sahu, R.K. Phytochemical evaluation and antioxidant activity of Piper cubeba and Piper nigrum. J. Appl. Pharm. Sci. 2011, 1, 153–157. [Google Scholar]
- Haq, S.; Abbasi, F.; Ben Ali, M.; Hedfi, A.; Mezni, A.; Rehman, W.; Waseem, M.; Khan, A.R.; Shaheen, H. Green synthesis of cobalt oxide nanoparticles and the effect of annealing temperature on their physiochemical and biological properties. Mater. Res. Express 2021, 8, 075009. [Google Scholar] [CrossRef]
- Haq, S.; Rehman, W.; Waseem, M.; Javed, R.; Mahfooz-ur-Rehman; Shahid, M. Effect of heating on the structural and optical properties of TiO2 nanoparticles: Antibacterial activity. Appl. Nanosci. 2018, 8, 11–18. [Google Scholar] [CrossRef]
- Sukumar, S.; Rudrasenan, A.; Padmanabhan Nambiar, D. Green-Synthesized Rice-Shaped Copper Oxide Nanoparticles Using Caesalpinia bonducella Seed Extract and Their Applications. ACS Omega 2020, 5, 1040–1051. [Google Scholar] [CrossRef]
- Mahfooz-Ur-Rehman, M.; Rehman, W.; Waseem, M.; Shah, B.A.; Shakeel, M.; Haq, S.; Zaman, U.; Bibi, I.; Khan, H.D. Fabrication of Titanium-Tin Oxide Nanocomposite with Enhanced Adsorption and Antimicrobial Applications. J. Chem. Eng. Data 2019, 64, 2436–2444. [Google Scholar] [CrossRef]
- Dhas, N.A.; Raj, C.P.; Gedanken, A. Synthesis, Characterization, and Properties of Metallic Copper Nanoparticles. Chem. Mater. 1998, 10, 1446–1452. [Google Scholar] [CrossRef]
- Keabadile, O.P.; Aremu, A.O.; Elugoke, S.E.; Fayemi, O.E. Green and traditional synthesis of copper oxide nanoparticles—Comparative study. Nanomaterials 2020, 10, 2502. [Google Scholar] [CrossRef]
- Hamid, A.; Haq, S.; Ur Rehman, S.; Akhter, K.; Rehman, W.; Waseem, M.; Ud Din, S.; Zain-ul-Abdin; Hafeez, M.; Khan, A.; et al. Calcination temperature-driven antibacterial and antioxidant activities of fumaria indica mediated copper oxide nanoparticles: Characterization. Chem. Pap. 2021, 75, 4189–4198. [Google Scholar] [CrossRef]
- Elemike, E.E.; Onwudiwe, D.C.; Singh, M. Eco-friendly Synthesis of Copper Oxide, Zinc Oxide and Copper Oxide–Zinc Oxide Nanocomposites, and Their Anticancer Applications. J. Inorg. Organomet. Polym. Mater. 2020, 30, 400–409. [Google Scholar] [CrossRef]
- Brindhadevi, K.; Samuel, M.S.; Verma, T.N.; Vasantharaj, S.; Sathiyavimal, S.; Saravanan, M.; Pugazhendhi, A.; Duc, P.A. Zinc oxide nanoparticles (ZnONPs) -induced antioxidants and photocatalytic degradation activity from hybrid grape pulp extract (HGPE). Biocatal. Agric. Biotechnol. 2020, 28, 101730. [Google Scholar] [CrossRef]
- Gusain, R.; Gupta, K.; Joshi, P.; Khatri, O.P. Adsorptive removal and photocatalytic degradation of organic pollutants using metal oxides and their composites: A comprehensive review. Adv. Colloid Interface Sci. 2019, 272, 102009. [Google Scholar] [CrossRef]
- Haq, S.; Ahmad, P.; Khandaker, M.U.; Faruque, M.R.I.; Rehman, W.; Waseem, M.; Din, S.U. Antibacterial, antioxidant and physicochemical investigations of tin dioxide nanoparticles synthesized via microemulsion method. Mater. Res. Express 2021, 8, 035013. [Google Scholar] [CrossRef]
- Shah, A.; Tauseef, I.; Arfat, M.; Ben, M.; Haq, S.; Elmnasri, K.; Al-harbi, M.S.; Kashif, S.; Hedfi, A.; Ben-attia, M. Histopathological and hematological investigations of mice model inoculated with nickel oxide nanoparticles and bacterial pathogens: In-vitro and in-vivo antibacterial studies. J. King Saud Univ. Sci. 2023, 35, 102456. [Google Scholar] [CrossRef]
- Shah, A.; Haq, S.; Rehman, W.; Muhammad, W.; Shoukat, S.; Rehman, M.U. Photocatalytic and antibacterial activities of Paeonia emodi mediated silver oxide nanoparticles. Mater. Res. Express 2019, 6, 045045. [Google Scholar] [CrossRef]
- Shah, A.; Tauseef, I.; Ali, M.B.; Yameen, M.A.; Mezni, A.; Hedfi, A.; Haleem, S.K.; Haq, S. In-Vitro and In-Vivo Tolerance and Therapeutic Investigations of Phyto-Fabricated Iron Oxide Nanoparticles against Selected Pathogens. Toxics 2021, 9, 105–120. [Google Scholar] [CrossRef]
- Gültekİn, D.D.; Güngör, A.A.; Önem, H.; Babagİl, A. Synthesis of Copper Nanoparticles Using a Different Method: Determination of Their Antioxidant and Antimicrobial Activity. Turk. Chem. Scociety 2016, 3, 623–636. [Google Scholar]
- Fouda, A.; Hassan, S.E.D.; Abdo, A.M.; El-Gamal, M.S. Antimicrobial, Antioxidant and Larvicidal Activities of Spherical Silver Nanoparticles Synthesized by Endophytic Streptomyces spp. Biol. Trace Elem. Res. 2020, 195, 707–724. [Google Scholar] [CrossRef] [PubMed]
- Study, P.; Rehman, F.U.; Mahmood, R.; Haq, S.; Ahmad, P.; Din, S.U. Phytogenic Fabrication of Copper Oxide Nanoparticles for Antibacterial and Antioxidant Screening: Physico-Chemical Study. Crystals 2022, 12, 1796. [Google Scholar]
- Al-fa, A.M.; Abu-kharma, M.H.; Awwad, A.M. Green synthesis of copper oxide nanoparticles using Bougainvillea leaves aqueous extract and antibacterial activity evaluation. Chem. Int. 2021, 7, 155–162. [Google Scholar]
- Andualem, W.W.; Sabir, F.K.; Mohammed, E.T.; Belay, H.H.; Gonfa, B.A. Synthesis of Copper Oxide Nanoparticles Using Plant Leaf Extract of Catha edulis and Its Antibacterial Activity. J. Nanotechnol. 2020, 2020, 2932434. [Google Scholar] [CrossRef]
- Rabiee, N.; Bagherzadeh, M.; Kiani, M.; Ghadiri, A.M.; Etessamifar, F.; Jaberizadeh, A.H.; Shakeri, A. Biosynthesis of Copper Oxide Nanoparticles with Potential Biomedical Applications. Int. J. Ofnanomed. 2021, 2021, 3983–3999. [Google Scholar] [CrossRef]
- Ramzan, M.; Obodo, R.M.; Mukhtar, S.; Ilyas, S.Z.; Aziz, F.; Thovhogi, N. Green synthesis of copper oxide nanoparticles using Cedrus deodara aqueous extract for antibacterial activity. Mater. Today Proc. 2020, 36, 576–581. [Google Scholar] [CrossRef]
- Velsankar, K.; Kumar, R.M.A.; Preethi, R.; Muthulakshmi, V.; Sudhahar, S. Green synthesis of CuO nanoparticles via Allium sativum extract and its characterizations on antimicrobial, antioxidant, antilarvicidal activities. Biochem. Pharmacol. 2020, 8, 104123. [Google Scholar] [CrossRef]
- Revathi, T.; Thambidurai, S. Cytotoxic, antioxidant and antibacterial activities of copper oxide incorporated chitosan-neem seed biocomposites. Int. J. Biol. Macromol. 2019, 139, 867–878. [Google Scholar] [CrossRef]
- Sisubalan, N.; Ramkumar, V.S.; Pugazhendhi, A.; Karthikeyan, C.; Indira, K.; Gopinath, K.; Hameed, A.S.H.; Basha, M.H.G. ROS-mediated cytotoxic activity of ZnO and CeO2 nanoparticles synthesized using the Rubia cordifolia L. leaf extract on MG-63 human osteosarcoma cell lines. Environ. Sci. Pollut. Res. 2018, 25, 10482–10492. [Google Scholar] [CrossRef]

| Bacteria | Antibiotics | CuO NPs Concentrations (5 mg/50 mL) | ||||
|---|---|---|---|---|---|---|
| 05 | 10 | 20 | 50 | 100 | ||
| S. aureus | 29.00 ± 01 | 18.6 ± 3.51 | 18.6 ± 1.52 | 20.00 ± 01 | 22.5 ± 2.51 | 24.00 ± 04 |
| S. epidermis | 24.3 ± 2.08 | 19.3 ± 2.51 | 19.6 ± 1.52 | 19.6 ± 0.57 | 21.6 ± 2.08 | 23.6 ± 1.52 |
| S. pyogens | 25.3 ± 5.03 | 17.3 ± 2.51 | 19 ± 2.64 | 20.00 ± 02 | 22.3 ± 1.52 | 21.3 ± 2.51 |
| E. coli | 27.6 ± 1.52 | 14.3 ± 4.03 | 18.6 ± 1.52 | 18.3 ± 0.57 | 20.3 ± 0.57 | 23.00 ± 01 |
| S. marcescom | 22.3 ± 7.50 | 15.00 ± 01 | 16.3 ± 4.50 | 17.00 ± 3.60 | 20.00 ± 01 | 24.3 ± 1.52 |
| K. pneumonia | 25.6 ± 4.04 | 14.6 ± 1.52 | 16.6 ± 0.52 | 16.3 ± 1.52 | 18.6 ± 1.52 | 20.3 ± 2.08 |
| Samples | Concentration (µg/mL) | %RSA | IC50 (µg/mL) | Variance (S2) | STD Deviation (S) | Correlation between Dose and Obtained Result |
|---|---|---|---|---|---|---|
| CuO NPs | 20 | 43 | 26 | 3.70 | 1.93 | 0.044 |
| 40 | 62 | |||||
| 60 | 73 | |||||
| 80 | 83 | |||||
| 100 | 97 | |||||
| Ascorbic acid | 20 | 26 | 66 | 4.38 | 2.10 | 0.067 |
| 40 | 38 | |||||
| 60 | 46 | |||||
| 80 | 58 | |||||
| 100 | 65 |
| Plant Source | Antibacterial Activity against Different Bacterial Strains (mm) | Antioxidant Activity | IC50 Value | References | |
|---|---|---|---|---|---|
| Pipper nigram leaves extract | S. aureus | 24 | 83.4% | 26 µg/mL | Current study |
| S. epidermis | 23.6 | ||||
| S. pyo | 21.3 | ||||
| E. coli | 23 | ||||
| S. marcescom | 24.3 | ||||
| K. pne | 20.3 | ||||
| Bougainvillea leaves extract | E. coli | 20 | [44] | ||
| S. aureus | 16 | ||||
| Catha edulis leaves extract | E. coli | 22 | [45] | ||
| S. aureus | 17 | ||||
| S. pyo | 29 | ||||
| K. pne | 16 | ||||
| Achillea millefolium leaves extract | E. coli | 28 | [46] | ||
| S. pyo | 17 | ||||
| S. aureus | 26 | ||||
| K. pne | 29 | ||||
| Cedrus deodara aqueous extract | E. coli | 29 | [47] | ||
| Allium sativum extract | E. coli | 8 | 96.09% | 40.52 µg/mL | [48] |
| S. aureus | 7 | ||||
| S. pyo | 8 | ||||
| K. pne | 8 | ||||
| Chitosan neem seed biocomposites | S. aureus | 17 | 56% | 91.05 µg/mL | [49] |
| E. coli | 16 | ||||
| Rubia cordifolia bark extract | 70.88% | [50] | |||
Disclaimer/Publisher’s Note: The statements, opinions and data contained in all publications are solely those of the individual author(s) and contributor(s) and not of MDPI and/or the editor(s). MDPI and/or the editor(s) disclaim responsibility for any injury to people or property resulting from any ideas, methods, instructions or products referred to in the content. |
© 2023 by the authors. Licensee MDPI, Basel, Switzerland. This article is an open access article distributed under the terms and conditions of the Creative Commons Attribution (CC BY) license (https://creativecommons.org/licenses/by/4.0/).
Share and Cite
Aien, J.; Khan, A.A.; Haq, S.; Khan, A.R.; Elmnasri, K.; Ben Ali, M.; AL-Harbi, M.S.; Alghonaim, M.I.; Alsalamah, S.A.; Qurtam, A.A.; et al. Antibacterial, Antioxidant and Physicochemical Properties of Pipper nigram Aided Copper Oxide Nanoparticles. Crystals 2023, 13, 330. https://doi.org/10.3390/cryst13020330
Aien J, Khan AA, Haq S, Khan AR, Elmnasri K, Ben Ali M, AL-Harbi MS, Alghonaim MI, Alsalamah SA, Qurtam AA, et al. Antibacterial, Antioxidant and Physicochemical Properties of Pipper nigram Aided Copper Oxide Nanoparticles. Crystals. 2023; 13(2):330. https://doi.org/10.3390/cryst13020330
Chicago/Turabian StyleAien, Javeria, Ashfaq Ahmad Khan, Sirajul Haq, Abdul Rehman Khan, Khaled Elmnasri, Manel Ben Ali, Mohammad S. AL-Harbi, Mohammed I. Alghonaim, Sulaiman A. Alsalamah, Ashraf A. Qurtam, and et al. 2023. "Antibacterial, Antioxidant and Physicochemical Properties of Pipper nigram Aided Copper Oxide Nanoparticles" Crystals 13, no. 2: 330. https://doi.org/10.3390/cryst13020330
APA StyleAien, J., Khan, A. A., Haq, S., Khan, A. R., Elmnasri, K., Ben Ali, M., AL-Harbi, M. S., Alghonaim, M. I., Alsalamah, S. A., Qurtam, A. A., Boufahja, F., Hedfi, A., & Dellali, M. (2023). Antibacterial, Antioxidant and Physicochemical Properties of Pipper nigram Aided Copper Oxide Nanoparticles. Crystals, 13(2), 330. https://doi.org/10.3390/cryst13020330

